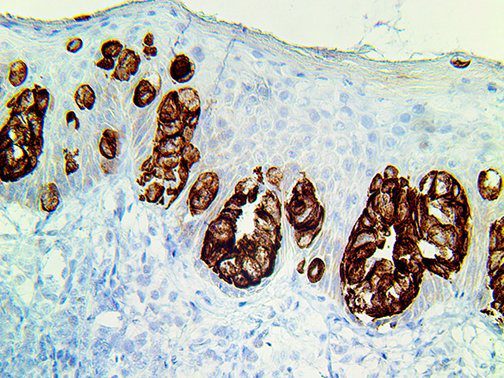

Fast Mohs IHC

Fast Mohs IHC Products
Reliable Fast Mohs IHC Antibodies Delivering Results in Just 10-20 Minutes!
Antibodies for fast IHC cancer detection after Mohs surgery.
Bio SB has developed high affinity IVD monoclonal antibodies for fast immunohistochemistry (IHC) detection of melanoma, basal cell carcinoma (BCC), squamous cell carcinoma (SCC) and other Mohs surgery related conditions. Combined with our innovative IHC detection systems, we are opening the doors to a faster and more accurate immunohistochemistry applicable to Mohs surgery.
Fast Mohs Detection Systems
Reliable IHC Detection Systems Delivering Results in Just 5-10 Minutes!
IHC detection systems for fast cancer detection after Mohs surgery.
Bio SB has developed a fast, non-biotin monovalent Fab micropolymer IHC detection system for the detection of IVD antibodies for melanoma, BCC, SCC and other Mohs surgery related conditions. Our innovative IHC detection systems have opened the doors for a faster and accurate immunohistochemistry applicable to Mohs surgery.
Fast Mohs Ancillaries